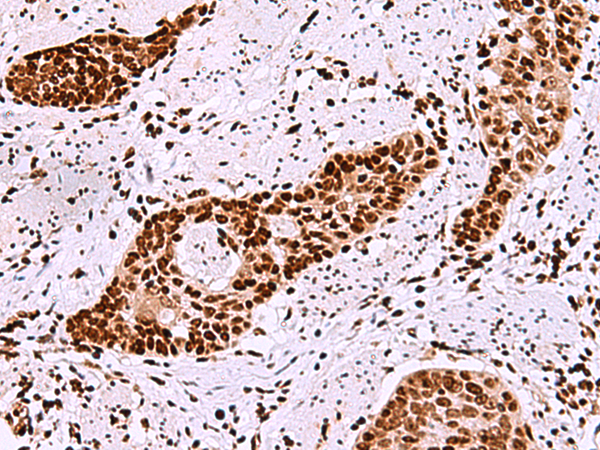

|
Background: |
Transcription repressor. Sequence-specific ssDNA and dsDNA binding protein, with preference for GCT end CTG repeats. Cell migration modulator which enhances the glioma-specific migration ability of neural stem cells (NSC) and neural precursor cells (NPC). |
|
Applications: |
ELISA, IHC |
|
Name of antibody: |
TMEM18 |
|
Immunogen: |
Synthetic peptide of human TMEM18 |
|
Full name: |
transmembrane protein 18 |
|
Synonyms: |
lncND |
|
SwissProt: |
Q96B42 |
|
ELISA Recommended dilution: |
5000-10000 |
|
IHC positive control: |
Human esophagus cancer and Human tonsil |
|
IHC Recommend dilution: |
30-150 |

購(gòu)物車
購(gòu)物車 幫助
幫助
 021-54845833/15800441009
021-54845833/15800441009
